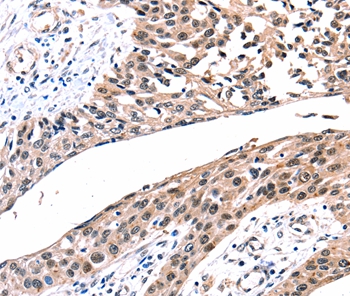

GJB2 / CX26 / Connexin 26 Antibody (Internal)
LS-C171540
ApplicationsWestern Blot, ImmunoCytoChemistry
Product group Antibodies
TargetGJB2
Overview
- SupplierLifeSpan BioSciences
- Product NameGJB2 / CX26 / Connexin 26 Antibody (Internal)
- Delivery Days Customer23
- ApplicationsWestern Blot, ImmunoCytoChemistry
- Applications SupplierICC, WB
- CertificationResearch Use Only
- ClonalityPolyclonal
- Concentration1 mg/ml
- ConjugateUnconjugated
- Estimated Purity...
- Gene ID2706
- Target nameGJB2
- Target descriptiongap junction protein beta 2
- Target synonymsBAPS; connexin 26; CX26; DFNA3; DFNA3A; DFNB1; DFNB1A; gap junction beta 2 proteinc; gap junction beta-2 protein; gap junction protein, beta 2, 26kDa; HID; KID; mutant gap junction beta 2 protein; mutant gap junction protein beta 2; NSRD1; PPK
- HostRabbit
- Storage Instruction-20°C,2°C to 8°C
- UNSPSC12352203